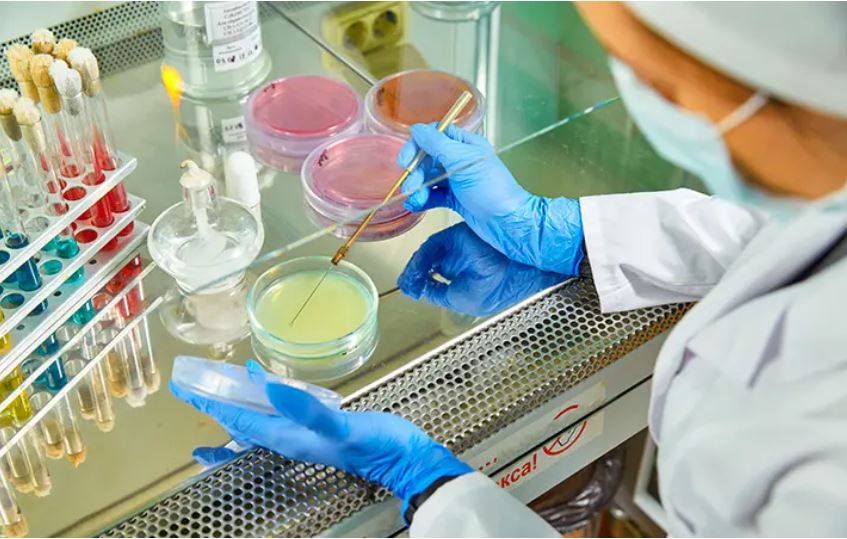
������ � 8:00 �� 11:00 � ��������� ����� ��������� ����� ������� �� ����������� � ����������

Новости за 12.06.2025
Дым видно за несколько километров от места крушения. Боинг летел по маршруту Ахмадабад-Лондон. Предположительно на борту было более 200 человек.
Эта информация совпадает с данными американской разведки, согласно которым Израиль намерен прекратить иранскую ядерную программу, уточняет The Washington Post.
Дорогие днестровцы!Поздравляем вас с Днём России — праздником, который объединяет всех, кому близки история, культура и ценности русского мира.Мы чувствуем особую связь с Россией — через язык, традиции, общую память и...
Конкурс посвящен дню фирмы «Шериф».Условия простые: напишите в комментариях под конкурсным постом в Инстаграме ТСВ что бы вы хотели выиграть. Всё! Итоги подведём...
К участию приглашаются журналисты, блогеры, фотографы и все творческие люди. Принимаются статьи, фото, репортажи, интервью, мультимедийные проекты, радио- и телесюжеты на русском, молдавском и украинском языках.Работы принимаются с 1 июля по 1 декабря...
Пора разбивать копилкиСегодня в Приднестровье стартовала «Монетная неделя». В любом банке можно обменять копейки на купюры. И никакой комиссии.Наш корреспондент Ира Жекова тоже в деле. Принесла 3 килограмма монет (!!!) – накопила за год
Электроснабжение быстро восстановили, сообщает ГУпЧС.
Акцию проводит Республиканский центр гигиены.Пер. Западный, 13Минздрав
12 июня – День России 12 июня 1990 года Первый съезд народных депутатов РСФСР утвердил Декларацию о государственном суверенитете.С 92-го года 12 июня объявлено нерабочим днем — тогда он назывался Днем принятия...
Для летней площадки средней школы N2 — день истории родного края.Полсотни школьников с 1 по 4 класс изучают экспонаты в залах природы, участвуют в викторинах, занимаются практической археологией, то есть изучают язык жестов первобытных людей, орудия...
Метеорологи обещают +23. Это на градус холоднее, чем сегодня.Не расстраивайтесь, на следующей неделе опять +29.
Познавательные игры и викторины, тематические и музыкальные часы, путешествия в страну сказок, показы мультфильмов позволяют сделать досуг детей не только интересным, но и полезным.К примеру, познавательная игра "Путешествие в страну Здравушка "...
«Молдова должна наращивать свои военные расходы, даже несмотря на нехватку финансирования здравоохранения или образования, поскольку республике предстоит в дальнейшем интегрироваться в более масштабные оборонительные структуры, а для этого...
На прошлой неделе зарегистрировано 100 случаев заболевания, почти половина — среди детей. У 22 заболевших выявлен возбудитель инфекции. Все тесты на холеру — отрицательные.Минздрав
Подростки из РУВК им. Макаренко побывали на территории гарнизона Оперативной группы российских войск. Для них 11 июня подготовили экскурсию.Воспитанникам закрытой школы рассказали о русской армии и гениальных полководцах со времён Александра Невского....
«Похоже, им начинает нравиться жить в условиях чрезвычайного положения. Но нельзя отрицать, что существуют серьезные проблемы с обеспечением левого берега энергетическими ресурсами. Цинизм Кремля не знает границ. Возможно, они попытаются повторить...
Эта махина весит больше 25 тонн, а в высоту будет 46 метров, как 15-этажный дом.Такую же установят и на другом берегу. А потом между ними протянут высоковольтные провода, которые питают Тирасполь и...
В Бендерах на автомобиль, припаркованный во дворе многоэтажки, упало дерево. Оно не выдержало порывов ветра. Спасатели освободили транспорт за 10 минут.Чтобы избежать подобных ситуаций, не паркуйте...
Купили айфоны за бумажкиУ 18-летнего тираспольчанина молодые люди украли четыре айфона. Потерпевший дал объявление в социальных сетях о продаже телефонов. «Покупатели» нашлись, но они решили рассчитаться неординарным способом: продавцу...
Увели из-под носаНаши друзья, гвардейцы из 119-го парашютно-десантного полка, делятся с нами эпичными кадрами. Бойцы увели из-под носа у украинских нацистов шведский Pansarbandvagn 302. Что интересно, в составе нашей группы, что отправилась на...